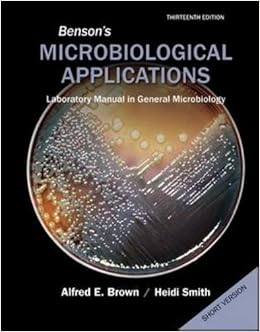

Microbiological Applications Lab Manual 12 Edition
Rac satnav 110 software. I would recommend this lab manual for students interested in supplementing their understanding of Microbiology with actual laboratory methods, or for professors looking for an easily comprehensible manual to teach their students anything from the basics of Microbiology to the more complicated Medical applications of the field!
Manual of Clinical Microbiology, 2 Volume Set, 12th Edition includes the latest applications of genomics and proteomics and is filled with current findings regarding infectious agents, leading-edge diagnostic methods, laboratory practices, and safety guidelines. This edition also features three new chapters on accreditation, Mycobacterium tuberculosis complex, and human herpesvirus 8.
This seminal reference of microbiology continues to set the standard for state-of-the-science laboratory practice as the most authoritative reference in the field of microbiology.
Benson’s Microbiological Applications has been the “gold standard” of microbiology laboratory manuals for over 35 years. This manual has a number of attractive features that resulted in its adoption in universities colleges and community colleges. These features include user-friendly diagrams that students can easily follow clear instructions and an excellent array of reliable exercises suitable for beginning or advanced microbiology courses. In revising the lab manual for the fourteenth edition we have tried to maintain the proven strengths of the manual and further enhance it.
We have updated the introductory material of the fungi protozoa and algae to reflect changes in scientific information. Finally the names of microorganisms used by the American Type Culture Collection. This is important for those users who rely on the ATCC for a source of cultures.